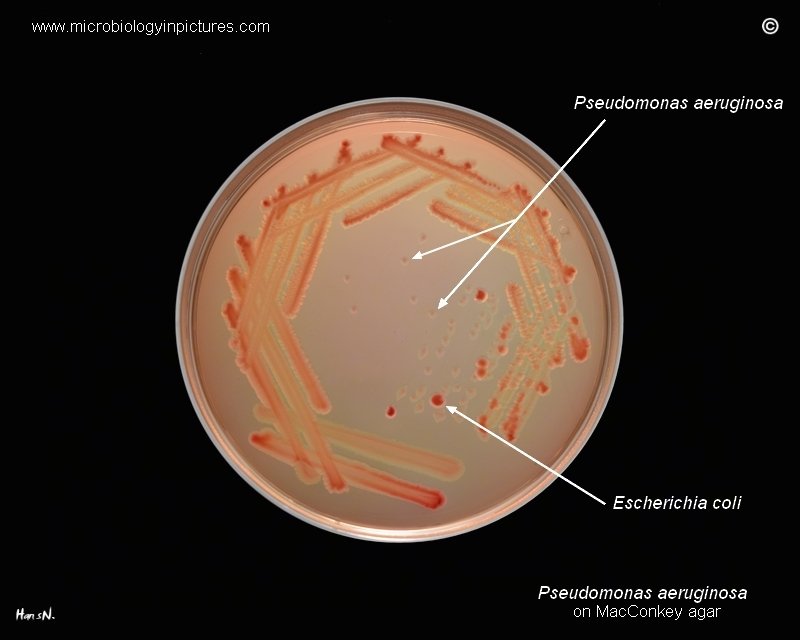
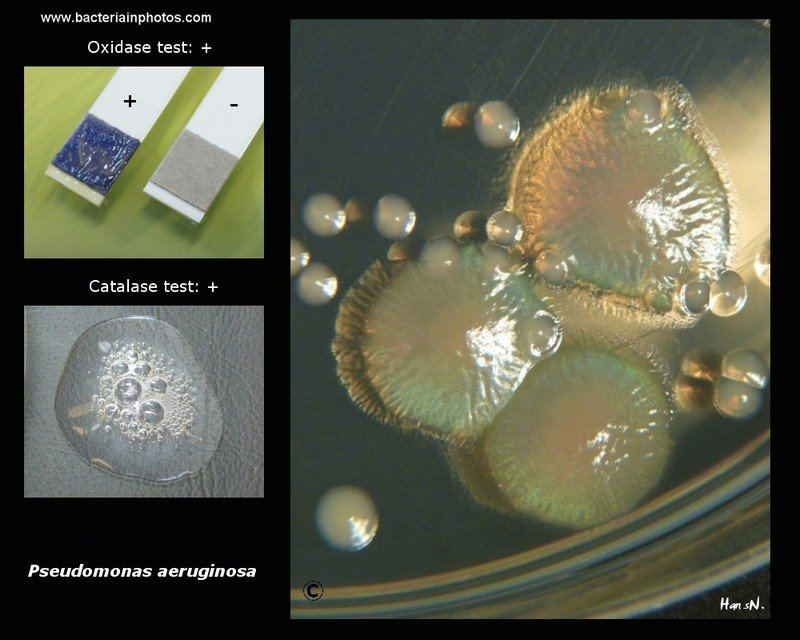
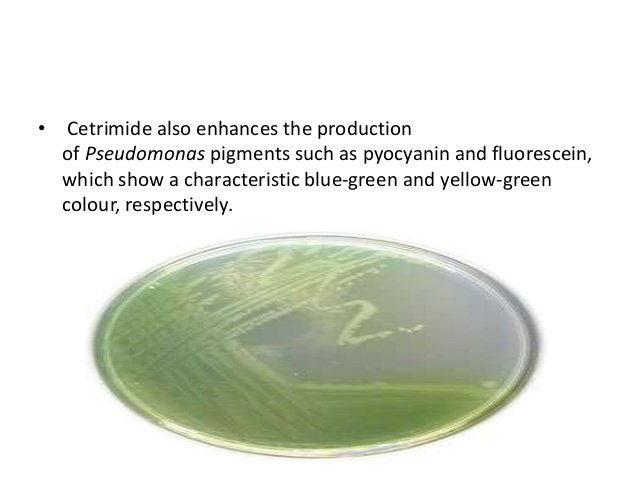

اكثر الأشخاص المعرضين لخطر الاصابه هم الأشخاص ذوي المناعه الضعيفه:
📍 مرضى السكر
📍الحوامل
📍مرضى الإيدز
📍المرضى المنومين في المستشفى وعلى اجهزه التنفس الصناعي.
📍المصابين بالحروق
📍مرضى السرطان
📍 مرضى السكر
📍الحوامل
📍مرضى الإيدز
📍المرضى المنومين في المستشفى وعلى اجهزه التنفس الصناعي.
📍المصابين بالحروق
📍مرضى السرطان
تتسبب هذي البكتريا بأمراض😣
كثيره منها :
📌التهابات المسالك البولية
📌التهابات الجهاز التنفسي
📌التهابات الجلد
📌التهابات الانسجة الرخوة
📌تسمم الدم
📌التهابات العظام والمفاصل
📌التهابات الجهاز الهضمي
📌العديد من الالتهابات والمشاكل الاخرى
كثيره منها :
📌التهابات المسالك البولية
📌التهابات الجهاز التنفسي
📌التهابات الجلد
📌التهابات الانسجة الرخوة
📌تسمم الدم
📌التهابات العظام والمفاصل
📌التهابات الجهاز الهضمي
📌العديد من الالتهابات والمشاكل الاخرى
ريحة بكتريا ال
Pseudomonas aerginosa
مميزه جدا
تم وصفها بأنها شبيهه برائحة( العنب)
"وانا اقول تشبه ريحه نوع من انواع الصابون بس مني عارفه اسمه" 🤔
ماعلينا نكمل 🤝
Pseudomonas aerginosa
مميزه جدا
تم وصفها بأنها شبيهه برائحة( العنب)
"وانا اقول تشبه ريحه نوع من انواع الصابون بس مني عارفه اسمه" 🤔
ماعلينا نكمل 🤝
عند عزل بكتيريا السيدوموناس من موقع يكون بالعاده معقم بطبيعته زي
(الدم، العظم،سائل النخاع الشوكي)
فا هنا نقدر نقول انه المريض في حاله خطر ويحتاج إلى العلاج بشكل عاجل جدا ‼️‼️
(الدم، العظم،سائل النخاع الشوكي)
فا هنا نقدر نقول انه المريض في حاله خطر ويحتاج إلى العلاج بشكل عاجل جدا ‼️‼️
طيب كيف طريقه علاج السيدوموناس؟ 💊🤔
Pseudomonas aerginosa
مقاومة لكثير من المضادات الحيوية المستخدمه😣
بالرغم انه كثير من سلالات البكتريا يتم علاجه باستخدام ال
Gentamicin, tobramycin, colistin, and amikacin.
بس كثير من السلالات هذي طورت مقاومتها للادويه المذكوره.
😶
Pseudomonas aerginosa
مقاومة لكثير من المضادات الحيوية المستخدمه😣
بالرغم انه كثير من سلالات البكتريا يتم علاجه باستخدام ال
Gentamicin, tobramycin, colistin, and amikacin.
بس كثير من السلالات هذي طورت مقاومتها للادويه المذكوره.
😶
وكثيرت ما يتم استخدام مزيج بين ال
Gentamicin & carbenicillin
لعلاج عدوى السيدوموناس الشديدة 💊
Gentamicin & carbenicillin
لعلاج عدوى السيدوموناس الشديدة 💊
تم بحمد الله 🙏🌹✨
جاري تحميل الاقتراحات...